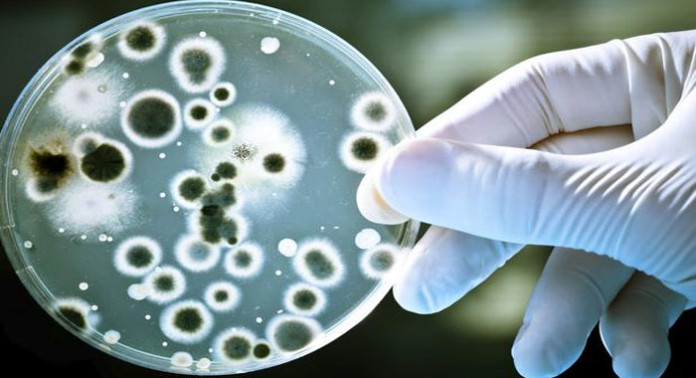

Apuntase otra razón por la cual sus bacterias intestinales son tan importantes para su salud – y por qué podrían ser la clave para prevenir una serie de enfermedades. Científicos de Suecia han descubierto que la flora intestinal humana regula los niveles del principal antioxidante, el glutatión del cuerpo, que combate una serie de enfermedades.
El estudio podría conducir a estudiar nuevos alimentos probióticos, y una mejor comprensión de los procesos metabólicos detrás de enfermedades como la diabetes tipo 2, dice el co-autor Adil Mardinoglu, investigador en biología de sistemas de KTH Royal Institute of Technology de Estocolmo.
Publicado en la revista científica Molecular Systems Biology, los resultados ayudan a completar nuestra comprensión de cómo se sintetizan aminoácidos no esenciales para dotar a las células del cuerpo con agentes desintoxicantes y antioxidantes, dice Mardinoglu.
«La microflora intestinal regula el metabolismo del glutatión y aminoácidos – no sólo en el intestino delgado, sino también en el hígado y el colon», dice.
El intestino delgado es sede de más de 1.000 conocidas especies diferentes de bacterias. Algunos de estas microbiotas resultaron ser consumidoras de glicina, que es uno de los tres aminoácidos requeridos para la síntesis de glutatión del cuerpo. En un ensayo con ratones libres de bacterias, los investigadores midieron el nivel de los aminoácidos en la vena porta, el vaso principal que drena la sangre desde el tracto gastrointestinal y el bazo al hígado. Encontraron un nivel más bajo de glicina en los tejidos del hígado y de colon, que indicaron que las bacterias del intestino regulaban el metabolismo del glutatión en esos órganos, también.
Mardinoglu señala que, dado que la disminución de los niveles de glicina y otros aminoácidos han sido vinculados a la diabetes tipo 2, enfermedad del hígado graso no alcohólico y otros trastornos relacionados con el metabolismo, el estudio adicional de aminoácidos microbiana en el tracto gastrointestinal humano podría arrojar luz sobre el desarrollo de estas enfermedades.
El vínculo entre las bacterias del intestino y el metabolismo del glutatión podría conducir al desarrollo de productos alimenticios que pueden proveer bacterias beneficiosas, o probióticos, al intestino, «dice Mardinoglu.» Estos resultados se pueden utilizar para comprender cómo las bacterias desempeñan un papel en los procesos metabólicos involucrados en el desarrollo de la obesidad, la diabetes tipo 2, la enfermedad no alcohólica del hígado graso, así como la mal nutrición «.






